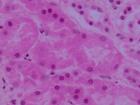
急驟進行性腎小球腎炎

基本信息
疾病名稱
急驟進行性腎小球腎炎
急驟進行性腎小球腎炎急驟進行性腎小球腎炎
疾病別名
RPGN
疾病分類
腎臟內科
疾病病因
注意發病前有無鏈球菌、結核桿菌、流感病毒等感染史,有無各種烴化物接觸史及服用肼苯噠嗪等藥物史,有無過敏性紫癜或系統性紅斑狼瘡等系統性疾病的臨床表現。
疾病概述
 急驟進行性腎小球腎炎
急驟進行性腎小球腎炎疾病描述
急進性腎小球腎炎(簡稱RPGN)是病情急驟進展的一組腎小球疾病。
症狀體徵
注意少尿、無尿出現的時間、尿量,及有無肉眼血尿、頭痛、噁心、嘔吐、心悸、氣急、咯血及其他出血徵象。體檢:同急性腎炎,但尚應注意意識、貧血、血壓和某些原發病的體徵。
診斷檢查
1、檢驗
胸片檢查,血清抗基底膜抗體、抗嗜中性粒細胞胞漿抗體(ANCA)、抗DNA抗體及抗核抗體測定,血找狼瘡細胞和皮膚活檢,以確定有無肺出血-腎炎綜合徵或結締組織疾病。常規行雙腎B超檢查,必要時行腎穿刺活檢。其他檢驗同原發性腎病綜合徵及急性腎炎。
2、臨床分型
(1)抗腎小球基底膜(抗GBM)抗體型(Ⅰ型):約占10%~30%,血清中可測到抗GBM抗體,循環免疫複合物陰性,補體水平正常。免疫螢光顯示,IgG及C3沿GBM呈線狀沉積,腎小球內炎症反應輕微,臨床貧血表現較突出。
(2)免疫複合物介導型(Ⅱ型):約占30%,血清中免疫複合物陽性,伴冷球蛋白血症及低補體血症,抗GBM抗體陰性,免疫螢光檢查可見IgG、IgM和C,在系膜區及毛細血管壁呈顆粒狀沉積,臨床上多表現為腎病綜合徵。
(3)微量免疫球蛋白型(Ⅲ型):約占50%,血清中抗GBM抗體及免疫複合物均陰性,血補體水平正常,部分患者ANCA抗體陽性,免疫螢光及電鏡檢查均未發現或僅有微量免疫球蛋白沉積,臨床上中、老年人多見,以乏力、體重下降、發熱、肌痛等為主要表現。
3、診斷標準:
(1)起病急驟、病情重,腎功能急劇損害以至尿毒症;
(2)除蛋白尿、血尿、管型尿外,少尿(<400ml/24h)或無尿突出;
(3)可有水腫、高血壓及迅速發展的貧血、低蛋白血症;
(4)腎組織檢查50%以上腎小球內有新月體形成;
(5)如無有效治療,多於半年至1年中死亡。
治療方案
1、有急性腎衰者按急性腎衰治療常規處理,積極行透析治療。循環中存在抗GBM抗體的患者可行血漿置換治療,直至該抗體在循環中不再檢出為止,對準備腎移植的患者尤為重要。
2、加強對症處理。伴有高血壓者,應予降壓,必要時靜脈注射快速降壓藥物;明顯貧血者應予輸血或用促紅細胞生成素治療;並發感染者應控制感染。
3、糖皮質激素、其他免疫抑制劑、肝素、潘生丁聯合治療。①潑尼松龍開始劑量60~100mg/d,(40mg/m2·d),1~3月內逐漸減到10~20mg/d。②環磷醯胺3mg/(kg·d),或硫唑嘌呤2mg/(kg·d)(當白細胞<4.0×109/L,應減量或停藥)。③肝素:劑量以血凝時間(試管法)延長至正常值的2~2.5倍為指標,成人用藥約6個月,以後改口服雙香豆素,其劑量以使凝血酶原時間延長一倍為度。④潘生丁:成人600mg/d,兒童10mg/(kg·d)。一般約治療1年後逐漸停用各種藥物。已出現少尿、無尿者無效。
4、大劑量糖皮質激素短程療法。甲基潑尼松龍15~30mg/(kg·d),每日最大劑量1000mg,溶於5%葡萄糖溶液250ml中,於1h內靜滴完畢。連用3日為一療程,最多可用3個療程。每個療程間隔1周,間歇期可用潑尼松30~40mg/d,口服。
5、雙衝擊治療。環磷醯胺靜脈注射0.5~1g/m2,每月1次,共6個月,伴甲基潑尼松龍500~1000mg/d,共3d,其後口服潑尼松60~100mg/d,3個月後逐漸減為30mg/d,再逐漸停藥。
6、纖溶療法,尿激酶15000~30000U/d,靜脈給藥,連續1~2周。
7、血漿置換法,套用膜式血漿分離器除去血漿,代之以等量正常人血漿或4%~5%白蛋白溶液。
8、如為Goodpasture綜合徵,經內科治療無效,可慎重考慮作雙腎截除術,以血透維持,待肺部病損得以改善後可行腎移植。
9、中藥活血化瘀治療,可用丹參、川芎製劑靜注或靜滴。
用藥安全
1、一般治療:臥床休息,進低鹽、低蛋白飲食,每日每公斤體重所給蛋白質量及水分可按急性腎炎原則處理。糾正代謝性酸中毒及防治高鉀血症。
2、皮質激素衝擊療法:甲基強的松龍,全療程為一年左右。該法對Ⅱ、Ⅲ型患者療效尚可。
3、四聯療法:即皮質激素、環磷醯胺、肝素、潘生丁聯合療法。皮質激素用量及方法同上;環磷醯胺每日150-200mg,靜注,每日1次,10次為1療程,總6-12g;肝素60-100mg,每日1次,靜注、靜滴或皮下注射;潘生丁200-300mg/日,分3次服。肝素與潘生丁4周為一療程,間歇7-10天可重複作用。總療程3個月至半年,該法在臨床上套用最多,其療效尚難肯定。
4、纖溶療法:尿激酶2-6萬u/日,加於5%葡萄糖液 20ml,靜注,或加於5%葡萄糖液250ml中靜滴,10次為1療程,間隔7天后,可行下一療程,總計3個療程。
5、血漿置換療法:目的在於清除血循環中抗原、抗體、免疫複合物及炎症性介導物質,目前多用血漿交換裝置,將血漿與血球分離,去除血漿,每次2至4升,每日或隔日1次,然後補回等量健康人新鮮血漿或4%人體白蛋白林格氏液。
6、抗氧化劑套用:因為氧自由基參與炎症損傷,目前有套用SOD及大劑量維生素E治療本病而取得療效。
7、一般治療:臥床休息,進低鹽、低蛋白飲食,每日每公斤體重所給蛋白質量及水分可按急性腎炎原則處理。糾正代謝性酸中毒及防治高鉀血症。
8、預後差,病死率高,5年生存率約25%;但也有報導新月體可以消失,病變可減輕,腎功能可望恢復,故應積極診治。

